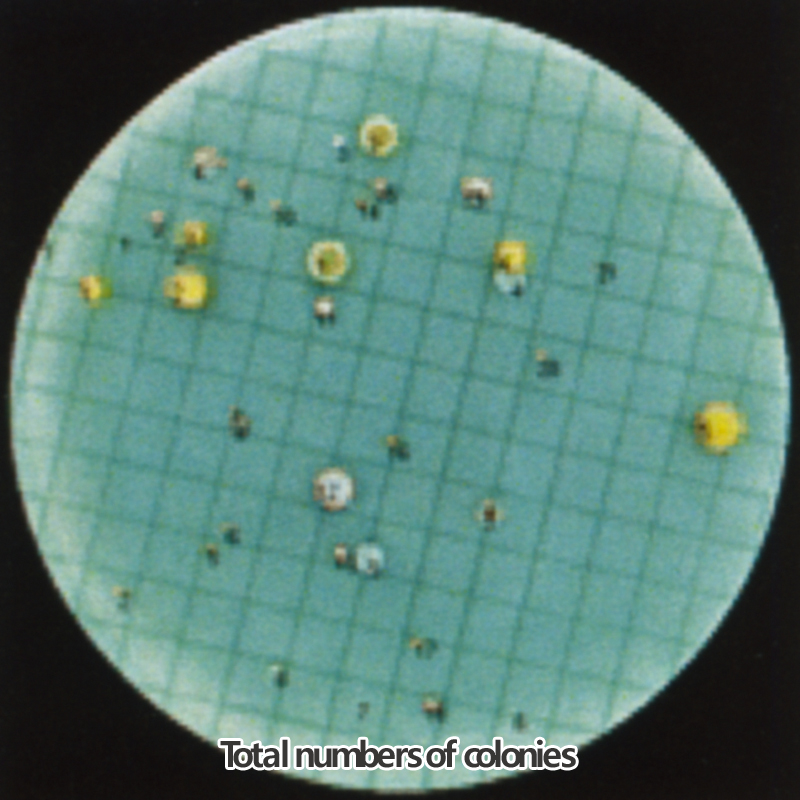

자동 세균 계수기 Automatic Colony Counter
구매 전 문의 부탁드립니다.

■ 주요특징
■ 콜로니의 Color, Size and Shape에 따라 Software를 선택 가능함
■ Light - Proof Sample Chamber with CCD - Firewire - Camera (색상)
■ Image Acquisition and Simultaneous Evaluation within Seconds
■ 테이블과 이미지가 디지털로 저장됨
■ Agar Plates, Nutrient Disks, Inhibition Zone Analysis, Spiral Plating
■ Mixed Cultures, up to 8 Colours Simultaneously per Petridish
■ Sectorial Evaluation, 90% Option
■ In Conformity with GLP
■ 기타 자세한 사항은 문의 요함
■ Schuett
| Cat. No | Model | Description |
|---|
| C23-108-550 | ColonyQuant | Automatic Colony Counter Set |
| Cat. No. | C23-108-550 |
|---|
| Model | Colony Quant |
|---|
| Resolution | 640×480 pixel |
|---|
| Illumination | From Below or Above Selectable |
|---|
| Size | w240×d290×h479 mm |
|---|
| Feature | Light - Proof Sample Chamber |
|---|
| Power | 100 ~ 240 V, 50/60 Hz |
|---|
전화문의 032-861-0282
이메일 vls0711@hanmail.net
